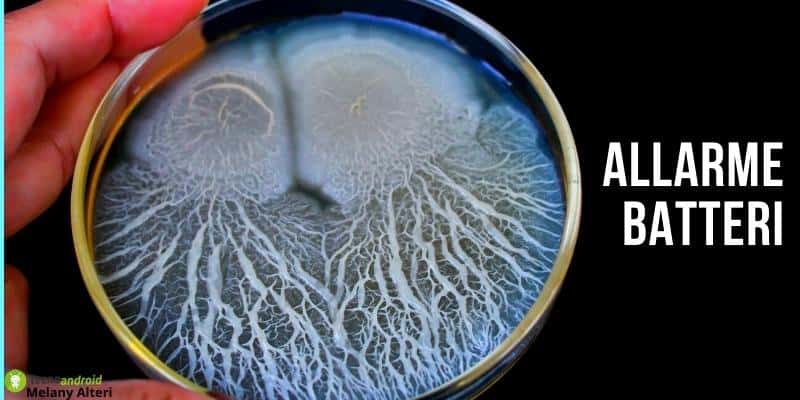

Volgendo lo sguardo verso il passato, noteremo che gli alimenti sottratti al mercato a partire dall’inizio dell’anno non sono affatto pochi. Ma non è ancora finita: giunti al sesto mese del 2022 siamo, come si suol dire a Roma, “da capo a dodici”. Ovvero, nonostante l’illusione della fine dei ritiri, ecco che ogni nostra certezza viene distrutta dall’ennesimo maxi ritiro alimentare del Ministero della salute.
Maxi ritiro alimentare: i nuovi prodotti coinvolti nella bufera
I prodotti sottoposti a maxi ritiro alimentare per via del Bacillus cereus e della salmonella sono:
- medaglioni di tofu con spinaci a marchio Natur Aktiv Bio Natura di Aldi per la “presenza di Bacillus cereus”. Peso 320 grammi, lotti numero 21170 con scadenza 14/01/2023, 21166 con scadenza 18/01/2023, 21079 con scadenza 15/04/2023 e 22292 con scadenza 14/09/2023.
- Rice Cakes – Gallette di riso al cioccolato fondente (cod. KLP1192) confezione da 70 gr. Tutti i lotti prodotti prima del 29/04/2022. Causa salmonella.
- Rice Cakes – Gallette di riso al cioccolato al latte (cod. KLP1166) confezione da 70 gr. Tutti i lotti prodotti prima del 29/04/2022
- Biscotti con gocce di cioccolato Elite (cod. KLP1128). Tutti i lotti prodotti prima del 29/04/2022 con relative date di scadenza, confezione da 180 gr.
- Vongole, della Pialassa della Baiona (area naturale protetta situata nel territorio del Comune di Ravenna). L’Unità operativa di Igiene degli alimenti di origine animale ha bloccato le attività di raccolta dei molluschi presenti nella zona.
- Pollo, marchio Carrefour, con sigla ‘Pollo allevato a terra origine Italia alette di pollo FQU’, il numero 0051000478, prodotto da C.A.F.A.R. e scadenza 10-02-2022.
È bene che voi sappiate anche che le malattie a trasmissione alimentare si distinguono di base in 3 tipi principali:
- Infezioni, dovute all’ingestione di alimenti con parassiti, virus o batteri vivi;
- Intossicazioni, alimenti in cui ci sono tossine già formate da batteri (vivi oppure no);
- Tossinfezioni, quando si ingeriscono batteri vivi che si moltiplicano all’interno dell’organismo producendo tossine e scorie.























